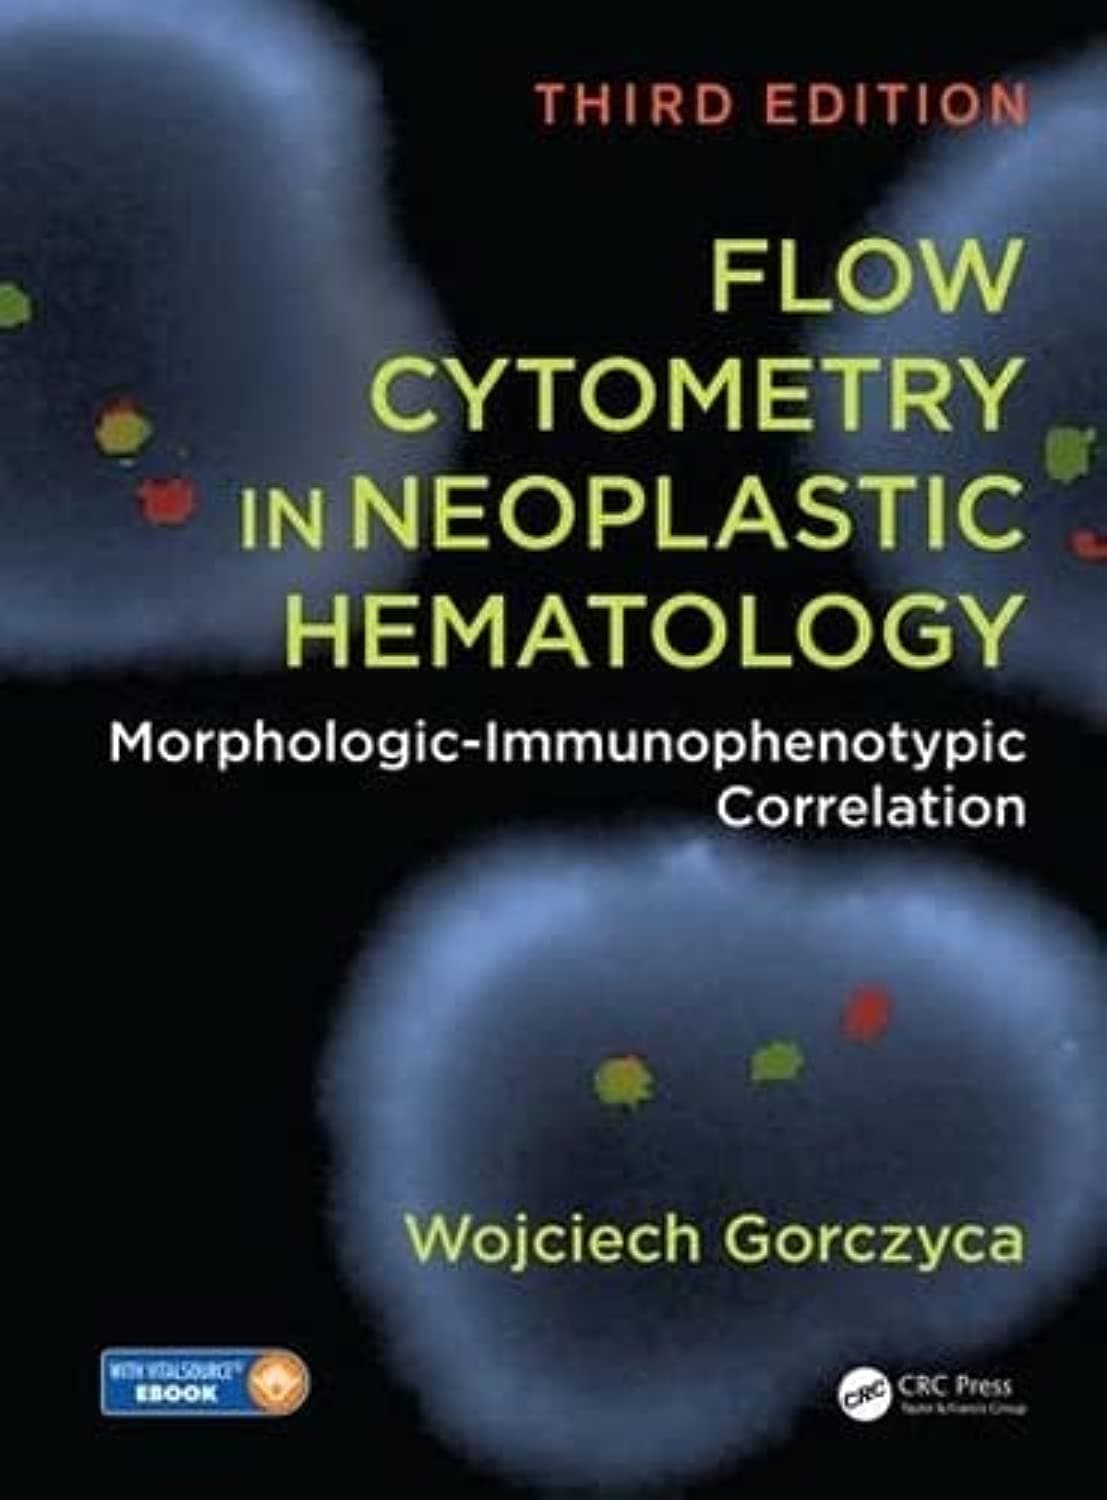
Flow Cytometry in Neoplastic Hematology: Morphologic-Immunophenotypic Correlation, Third Edition

Buy anything from 5,000+ international stores. One checkout price. No surprise fees. Join 2M+ shoppers on Desertcart.
Desertcart purchases this item on your behalf and handles shipping, customs, and support to Hong Kong.
Flow Cytometry in Neoplastic Hematology: Morphologic-Immunophenotypic Correlation, Third Edition
J**O
Five Stars
comprehensive
TrustPilot
1 个月前
2 周前
1 个月前
1天前